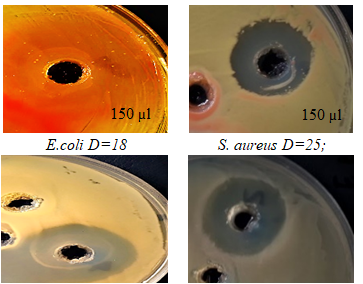

ỨNG DỤNG KỸ THUẬT ĐIỆN CAO ÁP TẠO PLASMA TRONG DUNG DỊCH TỔNG HỢP HẠT NANO SELEN VÀ ĐÁNH GIÁ KHẢ NĂNG KHÁNG KHUẨN CỦA VẬT LIỆU
Viện Hóa học - Vật liệu, Viện Khoa học và Công nghệ quân sự
17 Hoàng Sâm, Nghĩa Đô, Cầu Giấy, Hà Nội
Số điện thoại: 0862577688; Email: thienkqh140309@gmail.com
Nội dung chính của bài viết
Tóm tắt (Abstract)
SYNTHESIZING SELENIUM NANOPARTICLES USING HIGH VOLTAGE PLASMA GENERATION TECHNIQUE IN SOLUTION, EVALUATING THE ANTIBACTERIAL ABILITY OF THE MATERIAL
Selenium is an essential micronutrient for human, animal, and microorganism health. The biocompatibility, bioavailability, and low toxicity of selenium nanoparticles (SeNPs) have recently sparked the interest of scholars. Electrochemical plasma is a novel electrical discharge in a liquid environment, such as an aqueous solution or an organic compound. In this study, electrochemical plasma was utilized to synthesize SeNPs with a size range of 60 to 80 nm in water-ethanol mixtures. UVVisible Spectrophotometry (UV-Vis), X-Ray Diffraction (XRD), Raman spectroscopy, Scanning Electron Microscope (SEM), Energy dispersive spectroscopy and mapping (EDX), and X-ray photoelectron spectroscopy (XPS) were used to characterize the synthesized SeNPs. The obtained SeNPs showed good antimicrobial properties when testing with bacteria Staphylococcus aureus, Escherichia coli. The SeNPs showed effective bioactivity with inhibition zones of 18, and 25 mm against E. coli, and S. aureus, respectively, at a SeNPs dose of 150 µL (concentration of 300 ppm).
Từ khóa (Keywords)
Selenium nanoparticles, electrochemical plasma, anti-bacterial, Hạt nano selen, Kỹ thuật điện cao áp tạo plasma, Kháng khuẩn
Chi tiết bài viết
1. ĐẶT VẤN ĐỀ
Nguyên tố selen (Se) có tầm quan trọng lớn trong nhiều lĩnh vực như vật lý, hóa học và sinh học. Trong tự nhiên, selen tồn tại ở hai dạng: vô cơ (selen và selenat) và hữu cơ (selenomethionine và selenocysteine). Selen được tìm thấy ở dạng cấu trúc đa hình tinh thể và vô định hình trong tự nhiên. Selen đơn tà và tam giác là dạng tinh thể. Selen đơn tính (m-Se) có màu đỏ và chứa các vòng Se8. Selen thường tồn tại ở 3 trạng thái (α, β và γ), selen tam giác (t-Se) có màu đen và là dạng tinh thể ổn định nhất ở nhiệt độ phòng, selen vô định hình màu đỏ (a-Se), vô định hình đen và thủy tinh thể là các dạng selen không kết tinh [1]. Selen là nguyên tố vi lượng quan trọng, nó có ảnh hưởng rộng rãi đến các hệ thống sinh học, bao gồm các hiệu ứng chống oxy hoá, phòng chống ung thư và các hoạt động kháng virus [2, 3]. So với selen ở dạng ion, nano selen (SeNPs) có hoạt tính sinh khả dụng, hoạt tính sinh học cao hơn và độc tính thấp hơn [4-7]. Các tính chất sinh học của hạt nano Se phụ thuộc vào kích thước của chúng kích thước càng nhỏ sẽ có hoạt tính càng cao. SeNPs đã được tổng hợp ở nhiều dạng khác nhau như dạng hạt nano, dây nano, thanh nano thông qua nhiều phương pháp khác nhau như hóa học, hồi lưu, vi sóng, thủy nhiệt, bức xạ gamma, bắn phá bằng xung laser, và các phương pháp vật lý [8-11].
Công nghệ plasma hiện nay được ứng dụng trong nhiều lĩnh vực khác nhau như y tế, xử lý môi trường, tổng hợp vật liệu [12-14]. Plasma trong dung dịch xuất hiện trên hai điện cực khi áp vào hai đầu điện cực một điện áp hiệu điện thế cao từ vài đến vài chục kV, dưới tác động của điện trường mạnh gần điện cực, chất lỏng hóa hơi cục bộ bị ion hóa tạo thành plasma [15]. Plasma hình thành trong dung dịch chia thành hai vùng phản ứng riêng biệt: vùng plasma bao quanh điện cực và vùng pha lỏng gần plasma còn được gọi là vùng bề mặt tiếp xúc. Tại đó, trong vùng phản ứng xung quanh plasma, phân tử H2O bay hơi và phân ly thành H2, O2, lượng khí sinh ra không tuân theo định luật Faraday. Bên cạnh đó các gốc tự do H•, O•, OH•…, cũng được hình thành và khuếch tán vào dung dịch [16, 17]. Các gốc tự do phân tán vào dung dịch đóng vai trò là chất khử trong quá trình khử Se+4 thành Se0. Dung dịch phân tán hạt nano Se được tổng hợp bằng kỹ thuật điện cao áp tạo plasma trong dung dịch có độ tinh khiết cao mà không cần sử dụng thêm các tác nhân khử, phân tán trong môi trường nước sử dụng để nghiên cứu đánh giá các đặc trưng của vật liệu.
Trong nghiên cứu này, chúng tôi trình bày một số kết quả nghiên cứu tổng hợp hạt nano selen bằng kỹ thuật điện cao áp tạo plasma trong dung dịch và đánh giá khả năng kháng khuẩn của vật liệu.
2. THỰC NGHIỆM
2.1. Hóa chất - thiết bị
Hóa chất: Selen dioxit SeO2 99,9%, Merck; ethanol C2H5OH 99,7%, Gelon, Trung Quốc; Thanh vonfram 99,99%, Xilong, Trung Quốc.
Thiết bị: Bộ nguồn cao áp được cung cấp bởi hãng PEKURIS - Nhật Bản, máy hiện sóng oscilloscope Siglent SDS1104CFL 100 MHz, 4 CH.
Bảng 1. Đặc tính kỹ thuật thiết bị

2.2. Tổng hợp vật liệu
Dung dịch H2SeO3 được pha từ SeO2 trong nước cất 2 lần với nồng độ 10 mM xác định là dung môi cho quá trình phản ứng. Lấy 400 ml dung dịch cho vào bình phản ứng, gia nhiệt dung dịch phản ứng đến 70oC, bắt đầu tiến hành phóng điện cao áp. Sử dụng hệ điện cực kim loại vonfram với đường kính 3 mm, và khoảng cách giữa hai điện cực là 30 mm. Các điện cực được bọc trong ống nhựa teflon chịu nhiệt độ cao. Điện thế áp vào hai đầu điện cực 4 kV, tần số 25 kHz và độ rộng xung 3 µs. Hệ dung môi cho quá trình phản ứng là ethanol nồng độ 10%. Quá trình phản ứng được làm mát bằng nước tuần hoàn và sử dụng thiết bị hiện sóng oscilloscope để theo dõi độ ổn định của điện áp. Quy trình tổng hợp thể hiện trong Hình 1.

Hình 1. Thiết kế hệ phản ứng tổng hợp selen bằng kỹ thuật điện cao áp tạo plasma
2.3. Xác định đặc trưng của vật liệu
Xác định đặc trưng tính chất của vật liệu tổng hợp được thực hiện bằng máy quang phổ UV-vis UH-4150 HITACHI, Viện Hóa học - Vật liệu. Thành phần pha của các mẫu được phân tích bằng phương pháp nhiễu xạ tia X (XRD) trên thiết bị Mini flex 600 Rigaku (Nhật Bản) tại Đại học Khoa học - Tự nhiên, Đại học Quốc gia Hà Nội, nguồn tia CuKα, bước sóng λ=1.5406Ao, góc quét 2θ =20-70o, bước đo 0,03o/s và trên thiết bị Raman DXR3 Thermal Scientific tại Viện Hóa học - Vật liệu. Phân tích hình thái học và thành phần hóa học được xác định thông qua ảnh SEM kết hợp EDX được đo trên thiết bị HITACHI S-4800 tại Viện Khoa học Vật liệu (Viện Hàn lâm Khoa học và Công nghệ Việt Nam), XPS được phân tích tại đại học HanYang, Hàn Quốc.
Đánh giá khả năng kháng khuẩn được thực hiện tại Viện Công nghệ sinh học, Viện Hàn lâm Khoa học và Công nghệ Việt Nam. Phương pháp khuếch tán giếng tiêu chuẩn được sử dụng để nghiên cứu đặc tính kháng khuẩn của dung dịch phân tán hạt nano selen chống lại Echerichia coli và Staphylococcus aureus. Chúng tôi đã chế tạo các giếng 6 mm trên các đĩa thạch Muller-Hilton. Thể tích mẫu thử nghiệm lần lượt là 25, 50, 75 và 100 µL hạt nano selen với nồng độ 300 ppm và đối chứng ampicilline nồng độ 25µg/mL. Đường kình vòng tròn vô khuẩn của các mẫu được xác định sau khi ủ ở 37oC trong 24 giờ.
3. KẾT QUẢ VÀ THẢO LUẬN
3.1. Kết quả phân tích đặc trưng vật liệu
3.1.1. Kết quả UV-Vis

Dung dịch sau phản ứng được tiến hành quét quang phổ từ dải 190-1100nm, sự hình thành hạt nano selen trong dung dịch được xác định bằng các đỉnh hấp thụ trong khoảng từ 250-350 nm. Kết qua đo UV-Vis của các mẫu trước và sau khi tổng hợp được chỉ ra trong Hình 2. Với dung dịch H2SeO3 không thể hiện đỉnh hấp phụ trong dải bước sóng vùng UV-Vis, đối với dung dịch sau phản ứng có đỉnh hấp thụ đặc trưng ở bước sóng λmax ~ 300 nm, đỉnh hấp thụ này này được cho dao động plasmon bề mặt ở trạng thái kích thích của hạt nano selen. Điều này chứng tỏ sự hình thành hạt nano selen trong dung dịch bằng quá trình phóng plasma phù hợp với các công bố trước đó [18, 19].
3.1.2. Kết quả SEM
Hình thái bề mặt và cấu trúc hạt nano selen tổng hợp bằng kỹ thuật điện cao áp tạo plasma trong dung dịch được quan sát bằng ảnh SEM ở độ phóng đại khác nhau (Hình 3). Kết quả cho thấy các hạt selen tổng hợp bằng kỹ thuật điện cao áp tạo plasma trong dung dịch có dạng hình cầu, kích thước hạt phân bố trong dải từ 60÷80 nm.

Hình 3. Ảnh SEM ở độ phóng đại (a) 30k, (b) 50k,
(c) 100k và (d) 150k của hạt nano selen
3.1.3. Kết quả EDX
Nghiên cứu thành phần của hạt selen tổng hợp được bằng phổ tán xạ năng lượng tia X (Hình 4) cho thấy các mẫu hạt nano selen tổng hợp được ở trạng thái tinh khiết cao (đây là ưu điểm của kỹ thuật điện cao áp tạo plasma trong dung dịch). Sự hiện diện của các hạt nano selen đã được xác định bằng các đỉnh đặc trưng vào khoảng 1.4 keV và 11.2 KeV được quy cho SeLα và SeKβ của selen kim loại (hình 4a). Sự phân bố đồng đều và độ tinh khiết của mẫu hạt cũng được thể hiện bởi EDX-maping trong Hình 4b, 4c cũng như thành phần các nguyên tố trong Bảng 2. Mẫu được chuẩn bị với tấm đế silic, do đó xuất hiện đỉnh đặc trưng ở 1.7Kev của silic trên phổ đồ.

Hình 4. Phổ EDX (a) và mapping (b), (c) của hạt nano selen
Bảng 2. Thành phần hóa học của mẫu selen

3.1.4. Kết quả đo Raman, XRD và XPS
Kết quả phân tích phổ Raman khẳng định sự hình thành của hạt nano selen được tổng hợp bằng kỹ thuật điện cao áp tạo plasma trong dung dịch. Hình 5a và Hình 5b là phổ của SeO2 trước phản ứng và phổ của hạt nano selen. Phổ của SeO2 trước phản ứng có đỉnh cộng hưởng ở 825 cm-1, sản phẩm sau phản ứng chỉ ra duy nhất một đỉnh cộng hưởng ở 251 cm-1, đây là đỉnh cộng hưởng của selen tồn tại ở trạng thái α-Se tương ứng với selen có cấu trúc vô định hình [20]. Kết quả đo XRD (Hình 5c) cho thấy các cực đại nhiễu 2θ yếu xung quanh 23 và 29,5o, minh chứng rõ ràng hơn về trạng thái vô định hình của hạt nano selen.

Hình 5. Phổ Raman (a) SeO2, (b) Se0 và phổ XRD (c) của hạt nano selen
Kết quả phân tích quang phổ tia X (XPS) cho thấy rõ bản chất liên kết và hóa trị nguyên tố của selen. Hình 6 là phổ XPS của sản phẩm hạt nano selen cho các tín hiệu của C1, O1 và Se3d.

Hình 6. Phổ XPS của sản phẩm sau phản ứng
Đỉnh Se3d được tạo thành từ hai thành phần: Se 3d3/2 và Se 3d5/2 (Hình 7) tương ứng ở 56,04 và 55,28 eV. Đỉnh 3d Se0 của Se điển hình được tìm thấy ở 55,67, xác nhận rằng trạng thái hóa trị của Se trong Se-NP ở trạng thái cơ bản bởi vì Se+4 được có đỉnh peak ở khoảng 59,4 eV; Se+6 ở khoảng 61 eV; Se+2 ở khoảng 57,7 eV và Se-2 ở năng lượng liên kết <55 eV, hoàn toàn không xuất hiện trong phổ. Như vậy, chỉ tồn tại duy nhất trạng thái hóa trị 0 của Se trong sản phẩm. Còn tín hiệu của C1, O1 được xác định là của dung môi cồn C2H5OH tạo liên kết bề mặt với hạt Se0 hình thành lớp phủ bao bọc hạt trong quá trình tổng hợp.

Hình 7. Phổ phân giải cao XPS của selen (Se3d)
3.2. Cơ chế hình thành hạt nano selen trong dung dịch
Dưới tác dụng của plasma trong dung dịch, các gốc tự do như H·, OH·, O·... sinh ra phân tán vào dung dịch xảy ra quá trình khử Se+4 thành Se0 theo phản ứng:
H2O + e → H· + OH· (1)
SeO32- + 6H· → Se0 + 3H2O (2)
Ở đây gốc tự do H· đóng vai trò là chất khử chính trong việc khử Se+4 về Se0, do đó để tăng tốc độ phản ứng khử, thêm ethanol vào dung dịch nhằm tăng nồng độ các gốc tự do có khả năng khử Se4+ về Se0 [22].
CH3CH2OH + O· → ·CH(CH3)OH + HO (3)
CH3CH2OH + OH· → ·CH(CH3)OH + H2O (4)
·CH(CH3)OH + SeO32- → Se0 + CH3CHO + H2O (5)
Sự hình thành plasma trong dung dịch ở hai điện cực và quá trình khử Se4+ về Se0 được thể hiện trong Hình 8. Hình 8a là dung dịch H2SeO3 ban đầu trước khi phản ứng; sự xuất hiện plasma điện hóa ở hai đầu điện cực (Hình 8b) dẫn tới sự thay đổi màu của dung dịch; dung dịch chuyển dần sang màu đỏ chứng tỏ có sự hình thành của các hạt selen trong dung dịch (Hình 8c).

Hình 8. Sự hình thành plasma điện hóa và khử Se4+ về Se0 (a) dung dịch ban đầu, (b) sự hình thành plasma điện hóa ở 2 đầu điện cực, (c) sản phẩm sau phản ứng
3.3. Đánh giá khả năng kháng khuẩn của vật liệu
Kết quả xác định khả năng kháng khuẩn của dung dịch phân tán hạt nano selen được tổng hợp bằng kỹ thuật điện cao áp tạo plasma trong dung dịch đối với các chủng vi sinh vật được tiến hành ở nồng độ đầu vào selen là 300ppm.
Kết quả xác định khả năng kháng khuẩn của dung dịch phân tán hạt nano selen đối với 02 chủng vi khuẩn Staphyllococcus aureus; E.Coli được thể hiện trong Bảng 3 và Hình 9.
Bảng 3. Khả năng kháng khuẩn của vật liệu tổng hợp

Hình 9. Kết đo kháng khuẩn của mẫu vật liệu tổng hợp
Kết quả cho thấy dung dịch phân tán hạt nano selen có khả năng kháng khuẩn đối với chủng Staphyllococcus aureus; E. coli ở liều 150 µL với đường kính vòng tròn vô khuẩn lần lượt 25; 18 mm thì cho kết quả tương đương liều kháng sinh ampicilline đối chứng là 25 µg cho kết quả tương ứng là 26 và 20mm. Đây là cơ sở cho các nghiên cứu tiếp theo về độc tính cấp và hoạt tính sinh học của vật liệu nano selen tổng hợp bằng kỹ thuật điện cao áp tạo plasma trong dung dịch.
4. KẾT LUẬN
Trong bài báo này, chúng tôi đã thiết kế được hệ phản ứng, xây dựng quy trình và tổng hợp thành công hạt nano selen bằng kỹ thuật điện cao áp tạo plasma trong dung dịch mà không cần sử dụng thêm các chất khử hóa học với các thông số điện áp 4 kV, độ rộng xung 3 µs, tần số 25 kHz, điện cực vonfram có đường kính 3 mm, khoảng cách giữa 2 điện cực 30 mm. Các hạt nano selen được tổng hợp ở dạng hình cầu có kích thước nằm trong dải từ 60-80 nm, ở dạng vô định hình màu đỏ (a-Se), độ tinh khiết cao. Vật liệu tổng hợp được có khả năng ức chế các chủng Staphyllococcus aureus; E. coli (đường kính vòng tròn vô khuẩn lần lượt 25; 18 mm, thể tích tra mẫu 150 µL, nồng độ selen 300 ppm) tương đương với liều kháng sinh đối chứng ampicilline ở liều dùng 25 µg.
Lời cảm ơn: Nghiên cứu được sự hỗ trợ về kinh phí bởi Bộ Khoa học và Công nghệ cho nhiệm vụ cấp Quốc gia theo Nghị định thư, mã số NÐT.74.e-ASIA/19. Tập thể tác giả xin chân thành cảm ơn.
Tài liệu tham khảo
2. Institute of Medicine, Food and Nutrition Board, Dietary Reference Intakes: Vitamin C, Vitamin E, Selenium, and Carotenoids, National Academy Press, Washington, DC, 2000.
3. V. N. Gladyshev, Selenium: Its molecular biology and role in human health (3rd.), Springer, New York, 2006, p. 99-114.
4. S. Kumar, M. S. Tomar, A. Acharya, Carboxylic group-induced synthesis and char- acterization of selenium nanoparticles and its anti-tumor potential on Dalton's lymphoma cells, Colloids Surf. B: Biointerfaces, 2015, 126:546-552.
5. Wang H., Zhang J., Yu H., Elemental selenium at nano size possesses lower toxicity without compromising the fundamental effect on sele- noenzymes: comparison with selenomethionine in mice, Free Radic Biol. Med., 2007, 42(10):1524-1533.
6. Zhang J., Wang X., Xu T., Elemental selenium at nano size (Nano-Se) as a potential chemopreventive agent with reduced risk of selenium toxicity: comparison with Se-methylselenocysteine in mice, Toxicol Sci., 2008, 101(1):22-31.
7. Torres S. K., Campos V. L., León C. G., et al., Biosynthesis of selenium nanoparticles by Pantoea agglomerans and their antioxidant activity, J. Nanopart Res., 2012, 14(11):1236.
8. F. Sieber, et al., Elemental selenium generated by the photobleaching of seleno-merocyanine photosensitizers forms conjugates with serum macro-molecules that are toxic to tumor cells, Phosphorus Sulfur Silicon Relat Elem., 2005, 180:647-657.
9. F. Islam, et al., Selenium-induced alteration of lipids, lipid peroxidation, and thiol group in circadian rhythm centers of rat, Biol. Trace Elem. Res., 2002, 90:203-214.
10. B. T. Mayers, K. Liu, D. Sunderland and Y. Xia, Sonochemical Synthesis of Trigonal Selenium Nanowires, Chem. Mater., 2003, 15:3852-3858.
11. B. Yu, P. You, M. Song, Y. Zhou, F. Yu and W. Zheng, A facile and fast synthetic approach to create selenium nanoparticles with diverse shapes and their antioxidation ability, New J. Chem., 2016, 40:1118-1123.
12. Nguyễn Đức Hùng, Nguyễn Minh Thuỳ, Nguyễn Thanh Hải, Phan Thị Trang, Nguyễn Nhị Trự, Hiệu ứng điện ly plasma trong quá trình điều chế dung dịch nano bạc bằng dòng một chiều cao áp, Tạp chí Hóa học, 2014, 52(3):326-333.
13. T. Vasileiadis, V. Dracopoulos, M. Kollia, L. Sygellou and S. N. Yannopoulos, Synthesis of t-Te and a-Se nanospheres using continuous wave visible light, J. Nanopart. Res., 2019, 21:1-8.
14. Bittencourt J. A., Fundamentals of plasma physics, Springer, 2004, ISBN, 987-1-4419-1930-4.
15. Chae J. O., Non-thermal plasma for diesel exhaust treatment, Journal of Electrostatics, 2003, 57:251-262.
16. ELTayeb A., ELShazly A. H., Elkady M. F., Abdel Rahman A., Simulation and experimental study for degradation of organic dyes using dual pin-to-plate corona discharge plasma reactors for industrial wastewater treatment, Wiley Online Library, 2016.
17. Bruggeman P., Leys C., Non-thermal plasmas in and in contact with liquids, Journal of Physic. D: Applied Physic., 2009, 42:1-28.
18. Tomohito Sudare, Tomonaga Ueno, Anyarat Watthanaphanitad and Nagahiro Saito, Accelerated nanoparticles synthesis in alcohol-water-mixture-based solution plasma, Phys. Chem., 2015, 17:30255.
19. Mahsa Vahdati, Tahereh Tohidi Moghadam, Synthesis and characterization of selenium nanoparticles-lysozyme nanohybrid system with synergistic antibacterial properties, Scientific Reports, 2020, 10:510.
20. Aly H. Atta, Ahmed I., et al., Synthesis and characterization of some selenium nanometric compounds: Spectroscopic, biological and antioxidant assessment, World Journal of Nano Science and Engineering, 2014, 4:58-69.